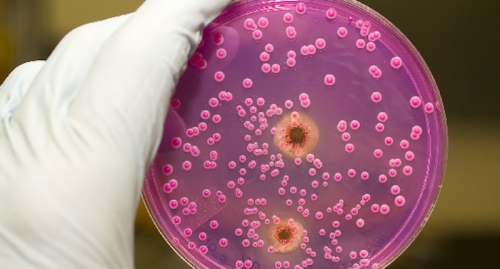

A New Choice For Colonoscopy Preparation
DANBURY, CT – January 24, 2008 – People sometimes avoid a colon cancer screening becausethey fear the inconvenience of the cleansing preparation more than the colonoscopy itself.Danbury Hospital is the first hospital in Connecticut and around the nation to offer